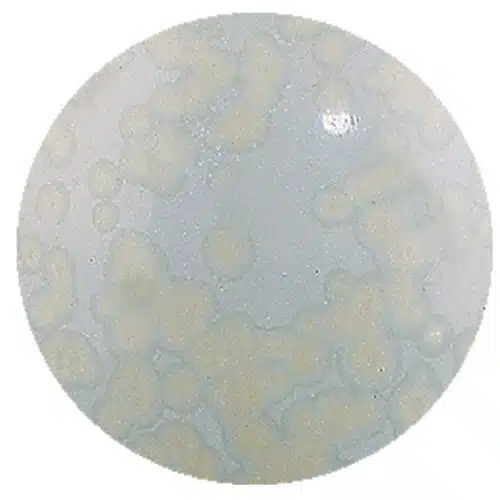
Magma MST842 steengoed wit mat kristaleffekt

- Home
- KERAMIEK
- BOETSEREN
- AFVORMEN
- Natuursteen bewerken
- Houtbewerken
- Metaalbewerken
- GIPS/CEMENT/HARS
- VERGULDEN/MOZAIEK
- ATELIERINRICHTING
- SOKKELS/ZUILEN
- BOEKEN/WAARDEBON
- WORKSHOPS
- AANBIEDINGEN
- SALE
- Merken
- Aanbiedingen
- Algemene Voorwaarden
- Veelgestelde vragen